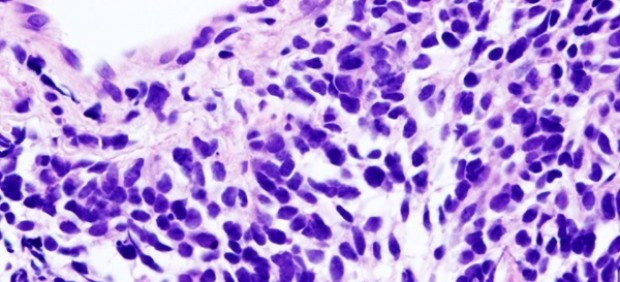
Carcinoma de pulmón de células pequeñas

EFE
El dispositivo brinda a los científicos la capacidad de estudiar las células y los tejidos de nuevas maneras.
Investigadores han desarrollado un 'órgano en un chip' tridimensional que permite la monitorización continua en tiempo real de las células y podría usarse para desarrollar nuevos tratamientos para enfermedades mientras reduce la cantidad de animales utilizados en la investigación.
El dispositivo, que incorpora células dentro de un transistor 3D hecho de un material similar a una esponja suave inspirado en la estructura del tejido nativo, brinda a los científicos la capacidad de estudiar las células y los tejidos de nuevas maneras. Al permitir que las células crezcan en tres dimensiones, el dispositivo imita con mayor precisión la forma en que las células crecen en el cuerpo.
Los científicos, liderados por la Universidad de Cambridge, Reino Unido, con colegas de Francia, Grecia y Arabia Saudita, dicen que su dispositivo podría modificarse para generar múltiples tipos de órganos: un hígado en un chip o un corazón en un chip, por ejemplo, lo que finalmente lleva a un cuerpo en un chip que simularía cómo diversos tratamientos afectan al cuerpo como un todo.
Tradicionalmente, los estudios biológicos se han realizado (y aún se hacen) en placas de Petri, donde se cultivan tipos específicos de células en una superficie plana. Aunque muchos de los avances médicos realizados desde la década de 1950, incluida la vacuna contra la poliomielitis, se originaron en las placas de Petri, estos entornos bidimensionales no representan con precisión los entornos tridimensionales nativos de las células humanas y, de hecho, pueden llevar a información engañosa y fallos de fármacos en ensayos clínicos.
"Los modelos celulares bidimensionales han sido muy útiles para la comunidad científica, pero ahora necesitamos pasar a modelos celulares tridimensionales para desarrollar la próxima generación de terapias", apunta el autor principal del estudio, Róisín Owens, del Departamento de Ingeniería Química y Biotecnología de Cambridge.
"Los cultivos celulares tridimensionales pueden ayudarnos a identificar nuevos tratamientos y saber cuáles evitar, si podemos monitorizarlos con precisión", dice el doctor Charalampos Pitsalidis, científico postdoctoral en el Departamento de Ingeniería Química y Biotecnología, y primer autor del estudio, cuyos resultados se detallan en la revista 'Science Advances'.
Ahora, los cultivos de células y tejidos en 3D son un campo emergente de la investigación biomédica, que permite a los científicos estudiar la fisiología de los órganos y tejidos humanos en formas que antes no eran posibles. Sin embargo, aunque se pueden generar estos cultivos en 3D, no se ha desarrollado bien la tecnología que evalúa con precisión su funcionalidad en tiempo real. "La mayoría de las células de nuestro cuerpo se comunican entre sí mediante señales eléctricas, por lo que, para monitorizar los cultivos celulares en el laboratorio, necesitamos conectarles electrodos --afirma Owens--. Sin embargo, los electrodos son bastante torpes y difíciles de unir a los cultivos celulares, por lo que decidimos cambiar todo el asunto y colocar las células dentro del electrodo".
El dispositivo que Owens y sus colegas desarrollaron se basa en un "andamio" de una esponja de polímero conductor, configurado en un transistor electroquímico. Las células se cultivan dentro del andamio y todo el dispositivo se ubica dentro de un tubo de plástico a través del cual pueden fluir los nutrientes necesarios para las células. El uso del suave electrodo de esponja en lugar de un electrodo de metal rígido tradicional proporciona un entorno más natural para las células y es clave para el éxito de la tecnología de órgano en un chip para predecir la respuesta de un órgano a diferentes estímulos.
Es necesario desarmar por completo otro órgano en un dispositivo de chip para monitorizar la función de las células, pero como el diseño dirigido por Cambridge permite el control continuo en tiempo real, es posible realizar experimentos a largo plazo sobre los efectos de diversas enfermedades y potenciales tratamientos.
"Con este sistema, podemos controlar el crecimiento del tejido y su salud en respuesta a medicamentos externos o toxinas -señala Pitsalidis-. Además de las pruebas de toxicología, también podemos inducir una enfermedad particular en el tejido y estudiar los mecanismos clave involucrados en esa patología o descubrir los tratamientos adecuados".
Los investigadores planean usar su dispositivo para desarrollar un 'intestino en un chip' y conectarlo a un 'cerebro en un chip' para estudiar la relación entre el microbioma intestinal y la función cerebral como parte del proyecto IMBIBE, financiado por el Consejo Europeo de Investigación. Los científicos han presentado una patente para el dispositivo en Francia.
.
Fecha: 30-10-18
Categoría: Tecnología
Leer Más
Todas las noticias